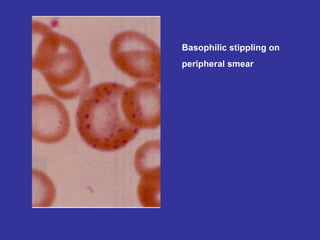
Basophilic stippling on  peripheral smear
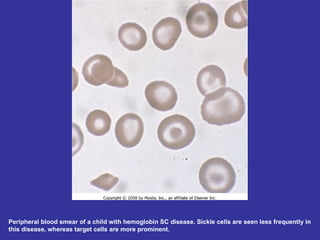
Peripheral blood smear of a child with hemoglobin SC disease. Sickle cells are seen less frequently in this disease, whereas target cells are more prominent.

Hematologic markers such as hemoglobin (Hb), hematocrit (Ht), mean corpuscular volume (MCV), and mean corpuscular hemoglobin concentration (MCHC) provide information about red blood cell (RBC) counts, size, and hemoglobin levels. Iron deficiency anemia results in microcytic, hypochromic RBCs and low levels of serum ferritin, iron, and transferrin saturation due to insufficient iron intake or absorption to support normal hemoglobin synthesis. Clinical presentation includes pallor, fatigue, and cardiovascular symptoms. Laboratory evaluation reveals microcytic RBCs on peripheral smear along with low Hb, Ht, MCV, MCH, and iron stores.